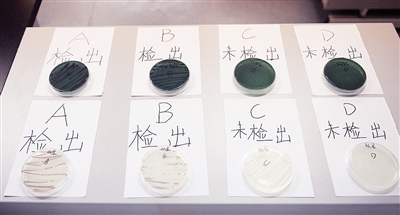

“吃货”注意了,警惕海鲜里的“致病杀手”
记者围观实验,专家支招如何安全吃海鲜
![]() |
| 残留菌种不可忽视 1 实验用的道具 |
![]() |
| 2 实验人员开始处理生带鱼 |
![]() |
| 3 擦拭完的砧板上处理熟食样品 |
![]() |
| 4 处理完的其中3份样品 |
![]() |
| 5 实验人员将样品依次放进装有实验试剂的容器内 |
![]() |
| 6 将样品接种于实验试剂中培养 |
![]() |
| 7 实验人员在实验室内进行副溶血性弧菌测试 |
![]() |
| 实验结果A、B样品均检出有副溶血性弧菌 8 |
本报记者 潘旭萍 陈立波 通讯员 嵇国强
醉虾醉蟹、三文鱼刺身、腌鱼……美味的海鲜,是每一个“吃货”挡不住的饕餮。但也总有人因为吃海鲜“闹肚子”,这是为什么?
昨天,杭州市市场监管局联合浙江大学开展了一场实验,记者在现场终于找到了这其中的罪魁祸首,参与此次实验的专家告诉记者,在尽情享用海鲜的时候,需警惕“副溶血性弧菌”食物中毒。
“海鲜中存在一种名叫‘副溶血性弧菌’的致病菌,进入人体胃肠道后,人体会出现恶心呕吐、腹痛腹泻、水样便等症状。尤其是体质差的人群,比如孕妇、老人、小孩等,反应更为明显。”浙江大学生物系统工程与食品科学学院教授沈立荣告诉记者,本次实验模拟家庭厨房环境,用砧板先后切海鲜、熟食,观察这种菌类会不会随着砧板、菜刀转移到熟食中。
实验室内,实验人员童盛芳早早准备好了象征海产品、熟食品的生带鱼和烤鸡。首先,她将生带鱼切成块状,放入样品A的袋中。随后,她用简单擦拭过的砧板、菜刀切烤鸡,部分烤鸡块放入样品B的袋中。最后,她另取了一套干净的砧板、菜刀,重新切了一次烤鸡块,这部分鸡块放入了样品C的袋中。同时,她将剩下的未切过的烤鸡块放入了样品D的袋中。
童盛芳将4组样品磨碎后进行前处理,并加入液体培养基进行增菌培养。“这一步的目的是,提取样品中残留的菌种,便于实验观测。”童盛芳将培养后的增菌液分离纯化后,在弧菌显色培养基上进行划线接种。
记者注意到,样品A检出了“副溶血性弧菌”,在培养基平板中呈连续分布状态;样品B也检出了该菌种,但数量较A少,呈断断续续分布状态,样品C、D均未检出该菌种。
“这说明,海鲜中常带有‘副溶血性弧菌’,处理过海鲜的砧板、菜刀上极易残留菌种,即便用水冲洗、简单擦拭过,也会在之后切熟食时,不小心将菌种带入熟食中。”沈立荣说道。
海鲜最好要煮熟食用
“‘副溶血性弧菌’有其生长条件,无盐的环境下不能繁殖,高温加热5-10分钟就会失活,食醋环境中1-3分钟就会死亡,并不会长期留存。”沈立荣建议,海鲜最好烧熟煮透,吃的时候可以选择搭配醋。至于刀具砧板,有条件的家庭可以备两套,分开切生食和熟食。若是只有一套用具,最好先切熟食再切海鲜,切过海鲜的用具一定要用高温、洗洁精清洗。
“‘副溶血性弧菌’主要生存在浅海地带,尤其贝类居多,所以煮贝类食品时必须在开口后继续煮5-10分才行。”沈立荣说,该菌种在深海环境中难以存活,因此喜欢吃三文鱼、北极贝等刺身的“吃货”不必太担心。
那么,食用风味独特的醉虾醉蟹,是否也有致病风险?“醉虾醉蟹一般用的湖虾湖蟹,主要问题是寄生虫,过量食用者极易感染肺吸虫病。”据悉,该病虫卵主要寄生在肺部,患者发病后,会咳嗽、呼吸困难、血痰、胸痛等。记者了解到,醉虾醉蟹的市场准入门槛高,一般要求厂商上报工艺标准,经审核通过才能入市,上市时间在每年11月到明年5月。“这是为了错开细菌、寄生虫的繁殖高发期。另外,不要网购三无醉虾醉蟹,消费者应该挑品牌购买。”沈立荣说。